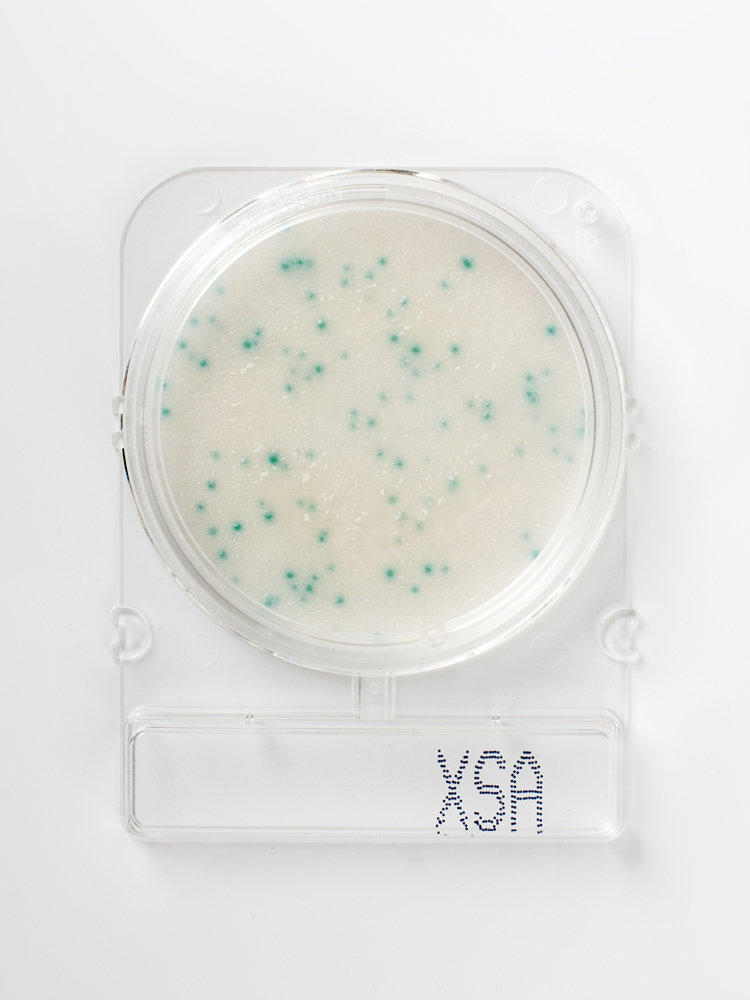

Compact Dry™ Prepared Media Plates - 54057
Compact Dry™ XSA
Staphylococcus aureus
35°C for 24 hours
Pack/100
54057
Compact Dry™ is a simple and safe procedure to determine and quantify microorganisms in food and beverage, raw materials, cosmetics and pharmaceutical industries and internal environmental monitoring. The ready-to-use Compact Dry™ chromogenic plates are suitable for both in-process and final product controls.
- Ready-to-use
- Self-diffusing media - no need for a spreader
- Room temperature storage vs competitive products with storage at temperatures less than or equal to 8ºC
- Rigid transparent plates with removable lid - no leakage
- Innovative stacking design
- Easy to label
- Ability to subculture without damage to colonies
- Widest available parameters and broadest application
- Convenient, fast and accurate results
Staphylococcus aureus is a microorganism present in the common human microflora, it can be found naturally on the skin and in the nose. Because of this, it is commonly used as an indicator of personal hygiene for food handlers. Staphylococcus aureus are normally harmless, at high levels can form endotoxins leading to “staph” food poisoning.
CAD$ 191 70
Quantity
1
Anything we can help with?
You've got questions, we've got answers.
Reach out and let's see what we can do together.